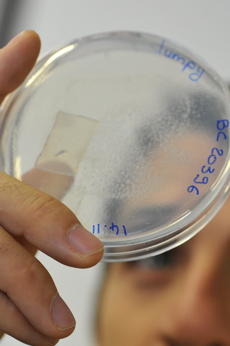

GENOME REGULATION AND EVOLUTION

Coordinated cellular activity in biological systems depends on sophisticated regulation of gene expression. In unicellular organisms, regulation allows survival in diverse environmental conditions. In multicellular organisms, differential expression of gene sets is essential for cell fate specification and organogenesis. We are especially interested in the regulatory processes involved in the development of metazoan organisms and how these processes arose during evolution. How can species with similar sets of genes evolve such a wide range of physiologies?
C. elegans is an ideal model to study the rules governing dynamic genetic programming of cell differentiation. Deciphering these processes in nematodes will provide a reference to understand more complex organisms and the evolutionary history of development.
We will explore regulatory networks of several nematodes to get insights in the evolution process of these mechanisms: how are loss and/or duplication of genes affecting the functional dynamics? Just like comparative genomics has proven tremendously powerful for genome annotation, comparative systems biology should help us understand how complex systems are modified, at the molecular level, throughout evolution to create diversity while preserving their main emerging properties.
The genome is the repository for all the genetic information that is needed to build a living organism. However, the DNA that constitutes the genome is also an active component of the cellular processes. Regulation of genetic activity is a central part of the response to environmental changes and a key player in cell differentiation and development. Our lab is focussing on studying mechanisms involved in gene regulation in vivo during the development of the nematode Caenorhabditis elegans. We use transgenic animals expressing fluorescent reporter proteins under the control of endogenous regulatory sequences. We then use a combination of microscopy and high-throughput quantitative analyses (or profiling, Dupuy, et al., 2007) to characterize these strains and dissect the functional organization of the regulation network.
C. elegans is the only metazoan organism to date for which all cell divisions have been mapped, the sequencing of its genome has been completed in 1998 it is therefore an extremely powerful experimental model for genomic and developmental studies.
KEYWORDS:
Gene expression, systems biology, functional genomics, development, evolution
C. elegans expressing Green Fluorescent Protein (GFP) in touch neurons under the control of the mec-7 promoter. Proper cell differentiation and function requires tight regulation of expression for specific sets of genes in time and in space.


Location :